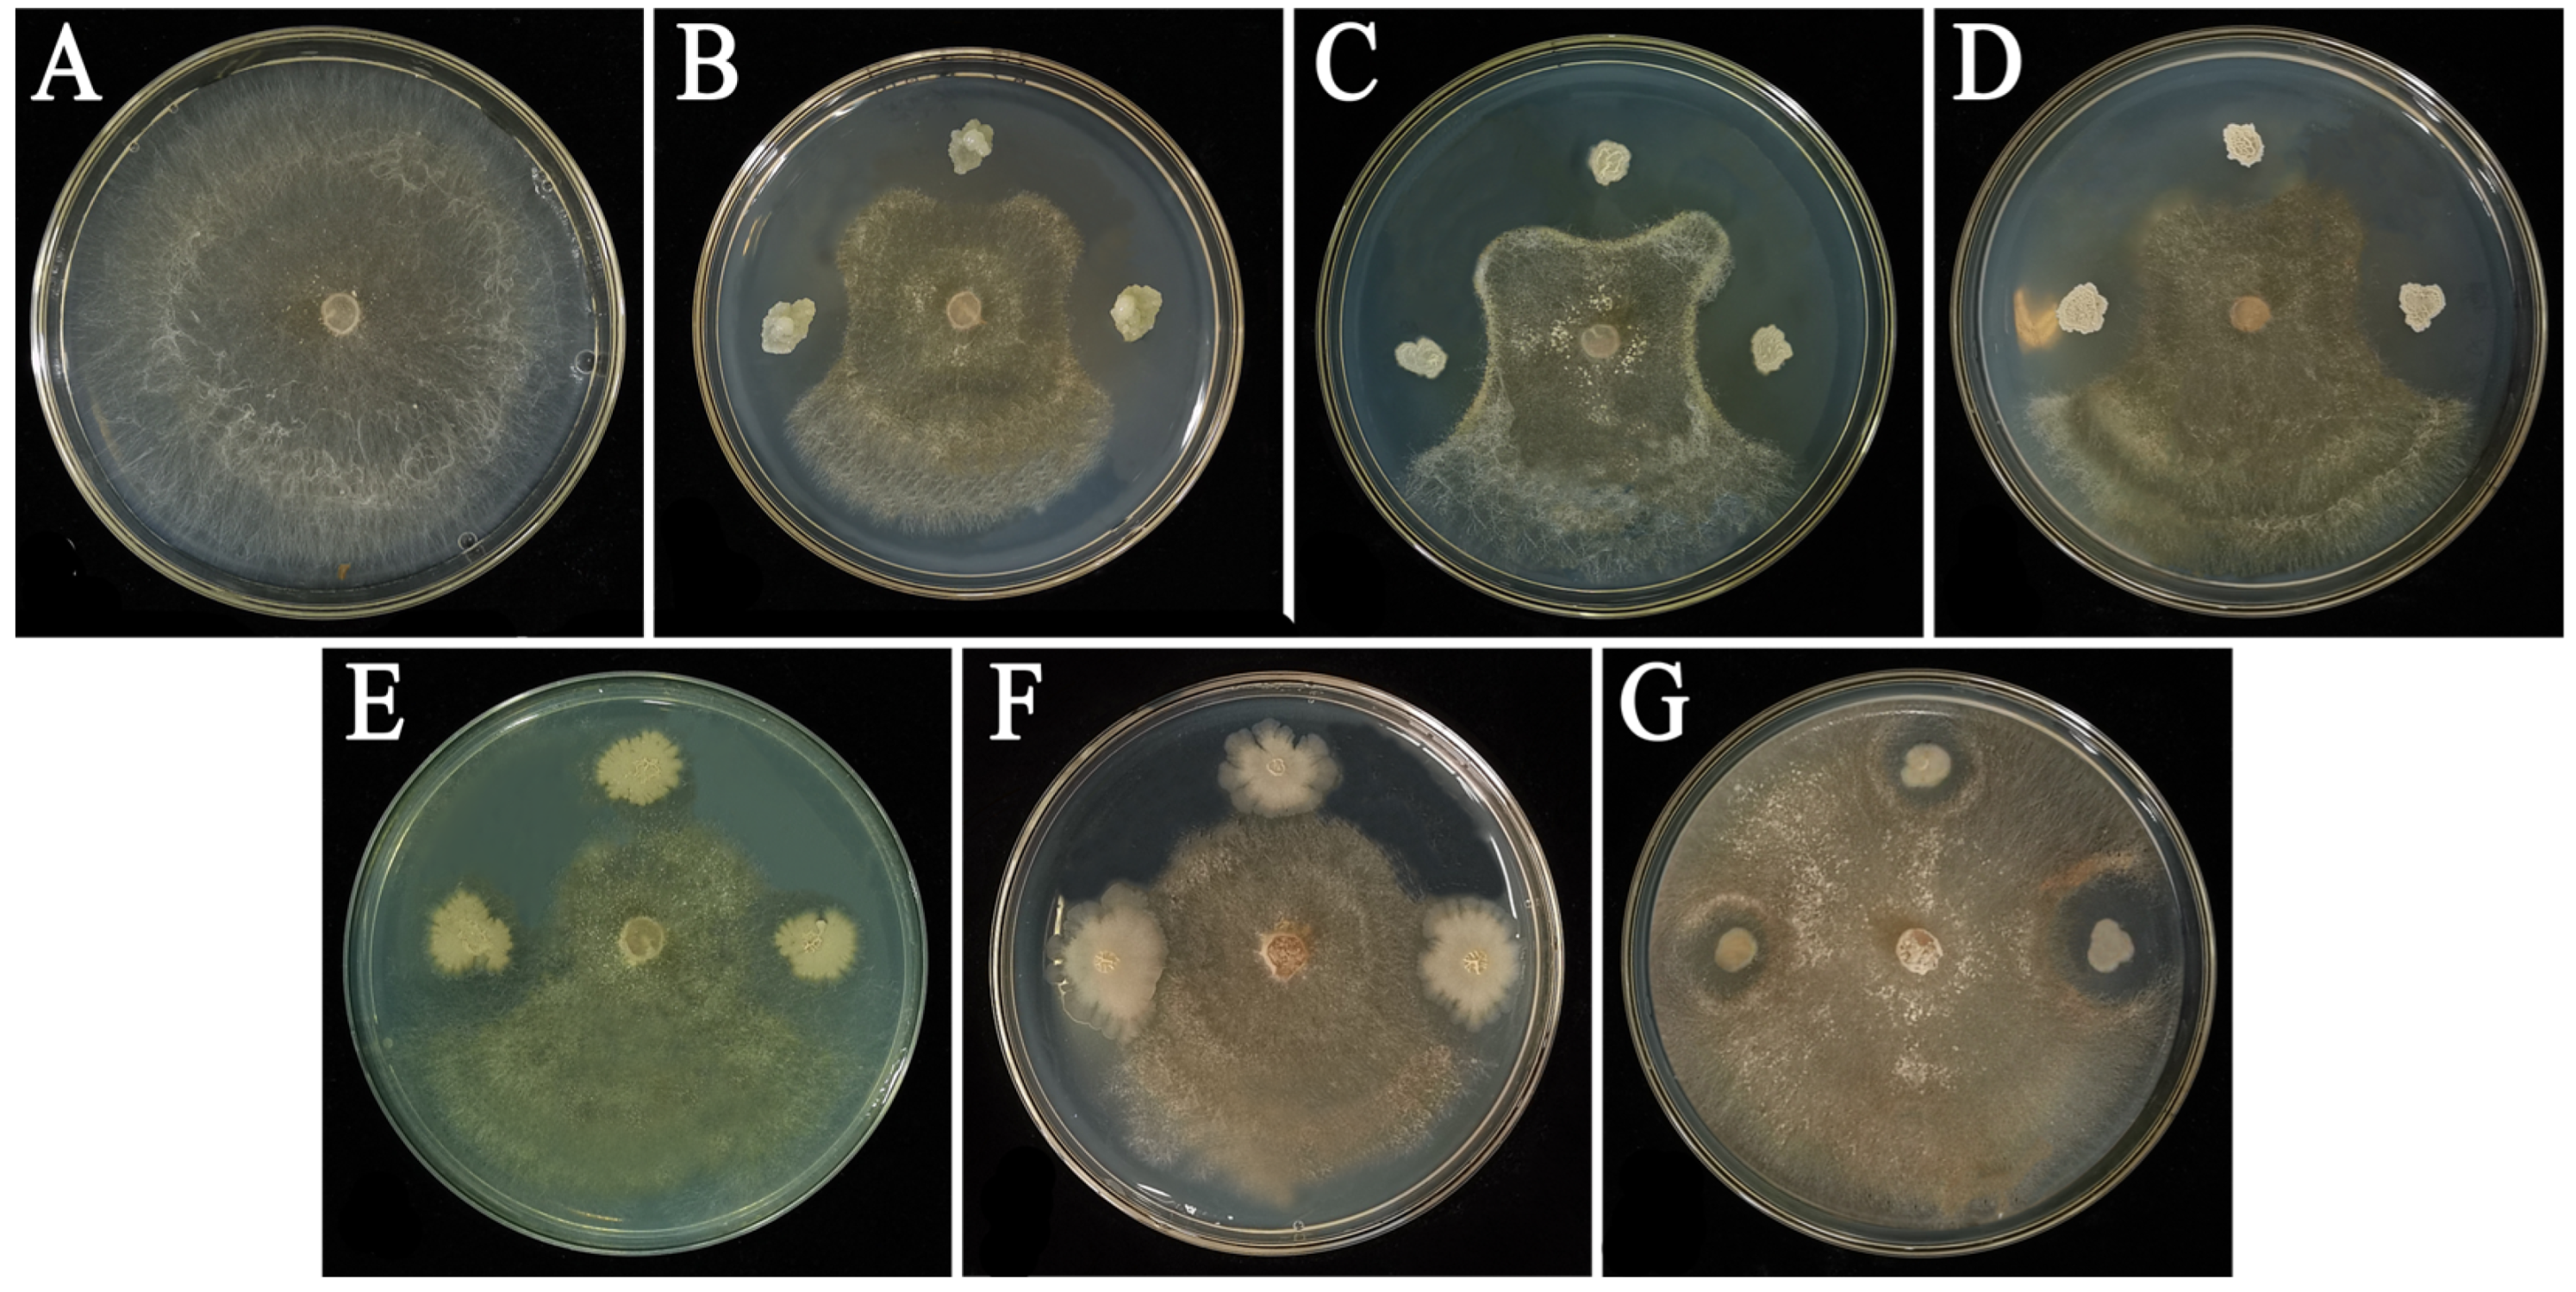
Agronomy 14 00351 g001

Biological Control Effect of Antagonistic Bacteria on Potato Black Scurf Disease Caused by Rhizoctonia solani
Abstract
1. Introduction
2. Materials and Methods
2.1. Pathogens Strain and Antagonistic Bacteria
2.2. Antifungal Activity Assay of P. polymyxa YF and B. amyloliquefaciens HT against R. solani
2.3. Determination of the Plant-Growth-Promotion Properties of P. polymyxa YF and B. amyloliquefaciens HT
2.3.1. Test of Siderophore Production
2.3.2. Detection of Extracellular Enzymes
2.3.3. IAA Production
2.4. Effect of P. polymyxa YF and B. amyloliquefaciens HT on Mycelial Morphology of R. solani
2.5. Effects of P. polymyxa YF and B. amyloliquefaciens HT on the Membrane Permeability of R. solani
2.6. Observation on Colonization of P. polymyxa YF Strain in Potato Plants
2.7. Control Effect on R. solani and Growth Promotion for Potato of P. polymyxa YF in the Greenhouse
2.8. Potato Excised Tissues Experiment
2.9. Production of Resistant Enzymes in Plants Induced by P. polymyxa YF
2.10. Detection of Synthesis Genes of Antimicrobial Lipopeptides of P. polymyxa YF and B. amyloliquefaciens HT
2.11. Identification of P. polymyxa YF Surfactin and Polymyxin B Sulfate Components by HPLC
2.12. Statistical Analysis
3. Results
3.1. Effect of P. polymyxa YF and B. amyloliquefaciens HT against R. solani
3.2. Effect of P. polymyxa YF and B. amyloliquefaciens HT on Mycelial Morphology of R. solani
3.3. Effects of P. polymyxa YF and B. amyloliquefaciens HT Culture Supernatant on Membrane Permeabilization
3.4. Determination of Biological Characteristics of Strains P. polymyxa YF and B. amyloliquefaciens HT
3.5. Observation on the Colonization of P. polymyxa YF in Potato Plants
3.6. Control Effect on R. solani and Growth Promotion of P. polymyxa YF in the Greenhouse
3.7. Detection of Antagonistic Enzyme Activities in Potato Plants
3.8. Detection of Synthesis Genes of Antimicrobial Lipopeptides of P. polymyxa YF and B. amyloliquefaciens HT
4. Discussion
5. Conclusions
Supplementary Materials
Author Contributions
Funding
Data Availability Statement
Conflicts of Interest
References
- Dennis, A.; Michael, K.T.; Jeffrey, S.M. Development of Rhizoctonia solani on Stems, Stolons and Tubers of Potatoes I. Eff. Inoculum Source 2010, 87, 374–381. [Google Scholar] [CrossRef]
- Adams, G.C. Thanatephorus cucumeris (Rhizoctonia solani) a species complex of wide host range. Adv. Plant Pathol. 1988, 6, 535–552. [Google Scholar] [CrossRef]
- Xie, K.Z.; Lu, L.Y.; Luo, A.H.; Hu, X.Y. Effect of long-term continuous cropping on soil-borne diseases and yield of potato. China Seed Ind. 2018, 2, 65–67. [Google Scholar] [CrossRef]
- Liu, X.J.; An, J.H.; Mo, J.; Sun, X.M.; Wang, W.H.; Wei, Z.Q.; Yang, Y. Field test of 5 fungicides against potato naevus disease. Chin. Potato J. 2019, 33, 170–174. [Google Scholar] [CrossRef]
- Ajayi-Oyetunde, O.O.; Bradley, C.A. Rhizoctonia solani: Taxonomy, population biology and management of rhizoctonia seedling disease of soybean. Plant Pathol. 2017, 67, 3–17. [Google Scholar] [CrossRef]
- Li, X.C.; Hou, H.H.; Liu, H.; Wang, H.C.; Cai, L.T.; An, M.N.; Zhang, C.; Wu, Y.H. Identification of 3-Methoxyphenylacetic Acid as a Phytotoxin, Produced by Rhizoctonia solani AG-3 TB. Molecules 2023, 28, 790. [Google Scholar] [CrossRef] [PubMed]
- Lehtonen, M.J.; Ahvenniemi, P.; Wilson, P.S.; German-Kinnari, M.; Valkonen, J.P.T. Biological diversity of Rhizoctonia solani (AG-3) in a northernpotato-cultivation environment in Finland. Plant Pathol. 2008, 57, 141–151. [Google Scholar] [CrossRef]
- Ceresini, P.C. Genetic diversity of Rhizoctonia solani AG-3 from potato and tobacco in North Carolina. Mycologia 2002, 94, 437–449. [Google Scholar] [CrossRef]
- Tuo, N.; Zhang, J.; Qiu, H.Z.; Zhang, W.M.; Zhang, C.H.; Liu, X.; Zhu, J. Pathogenic mechanism of R.solani potato blight I Micro-structure observation of the infection process and measurement of cell wall degradation enzyme activity. Acta Prataculturae Sin. 2015, 24, 74–82. [Google Scholar] [CrossRef]
- Zhao, Y.Z.; Wang, D.; Xu, L.M.; Jia, R.F.; Guo, J.S.; Li, N.; He, Y.Q.; Yan, H.M. Comparison of field control effect of different microbial inoculants on potato naevus disease. China Plant Prot. Guide 2020, 40, 90. [Google Scholar] [CrossRef]
- Larkin, R.P.; Honeycutt, C.W.; Griffin, T.S.; Olanya, O.M.; Halloran, J.M.; He, Z. Effects of different potato cropping system approaches and water management on soilborne diseases and soil microbial communities. Phytopathology 2011, 101, 58–67. [Google Scholar] [CrossRef]
- Ismail, S.; Jiang, B.; Nasimi, Z.; Inam-Ul-Haq, M.; Yamamoto, N.; Ofori, A.D.; Khan, N.; Arshad, M.; Abbas, K.; Zheng, A.P. Investigation of Streptomyces scabies causing potato scab by various detection techniques, its pathogenicity and determination of host-disease resistance in potato germplasm. Pathogens 2020, 9, 760. [Google Scholar] [CrossRef]
- Sakuma, F.; Maeda, M.; Takahashi, M.; Hashizume, K.; Kondo, N. Suppression of common scab of potato caused by Streptomyces turgidiscabies using lopsided oat green manure. Plant Dis. 2011, 9, 1124–1130. [Google Scholar] [CrossRef]
- Larkin, R.P.; Halloran, J.M. Management effects of disease-suppressive rotation crops on potato yield and soilborne disease and their economic implications in potato production. Am. J. Potato Res. 2014, 91, 429–439. [Google Scholar] [CrossRef]
- Bernard, E.; Larkin, R.P.; Tavantzis, S.; Hashizume, K.; Kondo, N. Rapeseed rotation, compost and biocontrol amendments reduce soilborne diseases and increase tuber yield in organic and conventional potato production systems. Plant Soil 2014, 374, 611–627. [Google Scholar] [CrossRef]
- Jung, W.; Park, R.; Mabood, F.; Hashizume, K.; Kondo, N. Effects of Pseudomonas aureofaciens 63-28 on defense responses in soybean plants infected by Rhizoctonia solani. J. Microbiol. Biotechnol. 2011, 21, 379–386. [Google Scholar] [CrossRef] [PubMed]
- Gutierrez, J.; Bakke, A.; Vatta, M.; Merrill, A.R. Plant natural products as antimicrobials for control of Streptomyces scabies: A causative agent of the common scab disease. Front. Microbiol 2021, 12, 4334. [Google Scholar] [CrossRef] [PubMed]
- González, V.; Armijos, E.; Garcés-Claver, A. Fungal endophytes as biocontrol agents against the main soil-borne diseases of melon and watermelon in Spain. Agronomy 2020, 10, 820. [Google Scholar] [CrossRef]
- Bustamante, M.I.; Elfar, K.; Eskalen, A. Evaluation of the Antifungal Activity of Endophytic and Rhizospheric Bacteria against Grapevine Trunk Pathogens. Microorganisms 2022, 10, 2035. [Google Scholar] [CrossRef] [PubMed]
- Abo-Elyousr, K.A.M.; Saad, M.M.; Al-Qurashi, A.D.; Ibrahim, O.H.M.; Mousa, M.A.A. Management of Cumin Wilt Caused by Fusarium oxysporum Using Native Endophytic Bacteria. Agronomy 2022, 12, 2510. [Google Scholar] [CrossRef]
- Samaras, A.; Roumeliotis, E.; Ntasiou, P.; Karaoglanidis, G. Bacillus subtilis MBI600 promotes growth of tomato plants and induces systemic resistance contributing to the control of soilborne pathogens. Plants 2021, 10, 1113. [Google Scholar] [CrossRef]
- Ahmed, W.; Zhou, G.; Yang, J.; Munir, S.; Ahmed, A.; Liu, Q.; Ji, G. Bacillus amyloliquefaciens WS-10 as a potential plant growth-promoter and biocontrol agent for bacterial wilt disease of flue-cured tobacco. Pest Control 2022, 32, 25. [Google Scholar] [CrossRef]
- Platel, R.; Sawicki, M.; Esmaeel, Q.; Randoux, B.; Trapet, P.; Guilli, M.E.; Chtaina, N.; Ségolène, A.; Alexandre, B.; Rochex, A.; et al. Isolation and Identification of Lipopeptide-Producing Bacillus velezensis Strains from Wheat Phyllosphere with Antifungal Activity against the Wheat Pathogen Zymoseptoria tritici. Agronomy 2022, 12, 95. [Google Scholar] [CrossRef]
- Emre, D.D. Biological control of Rhizoctonia solani on potato by using indigenous Trichoderma spp. AIP Conf. Proc. 2016, 1726, 020020. [Google Scholar] [CrossRef]
- Franziska, F.; Jana, L.; Rita, G.; Gabriele, B. Strategy to select and assess antagonistic bacteria for biological control of Rhizoctonia solani Khn. Can. J. Microbiol. 2004, 50, 811–820. [Google Scholar] [CrossRef]
- Grosch, R.; Scherwinski, K.; Jana, L.; Berget, G. Fungal antagonists of the plant pathogen Rhizoctonia solani: Selection, control efficacy and influence on the indigenous microbial community. Mycol. Res. 2006, 110, 1464–1474. [Google Scholar] [CrossRef]
- Moncef, M.; Naceur, D.; Salem, E.; Youssra, M.; Sabrine, S.; Belhassen, T.; Ridha, M. Efficacy of selected Pseudomonas strains for biocontrol of Rhizoctonia solani in potato. Phytopathol. Mediterr. 2013, 52, 449–456. [Google Scholar] [CrossRef]
- Elham, K.; Naser, S.; Masoud, S.B.; Bagher, M. Bacillus amyloliquefaciens SB14 from rhizosphere alleviates Rhizoctonia damping-off disease on sugar beet. Microbiol. Res. 2016, 192, 221–230. [Google Scholar] [CrossRef]
- Saoussen, B.K.; Olfa, K.F.; Mouna, D.; Hayfa, J.K.; Mejda, D.R.; Slim, T. Efficacy of Bacillus subtilis V26 as a biological control agent against Rhizoctonia solani on potato. C R Biol. 2015, 338, 784–792. [Google Scholar] [CrossRef]
- Bric, J.M.; Bostock, R.M.; Silverstone, S.E. Rapid in situ assay for indoleacetic Acid production by bacteria immobilized on a nitrocellulose membrane. Appl. Environ. Microbiol. 1991, 57, 535–538. [Google Scholar] [CrossRef] [PubMed]
- Dorra, B.A.; Olfa, F.G.; Slim, T. Rizhospheric competence, plant growth promotion and biocontrol efficacy of Bacillus amyloliquefaciens subsp. plantarum strain 32a. Biol. Control 2018, 124, 61–67. [Google Scholar] [CrossRef]
- Yang, Y.G.; Wu, X.H. First Report of Potato Stem Canker Caused by Rhizoctonia solani AG4 HGII in Gansu Province, China. Plant Dis. 2013, 97, 840. [Google Scholar] [CrossRef] [PubMed]
- Zhang, Z.K.; Zhang, W.X.; Wang, X.F.; Kou, Z.A.; Wang, Y.L.; Rehmat, I.; Zhang, J.Q.; Liu, L.; Shen, T.; Tian, Y.Q. Isolation and identification of antagonistic bacteria of Angelica root rot and their mechanism as biological control. Biol. Control 2022, 177, 105120. [Google Scholar] [CrossRef]
- Jiang, C.-H.; Liao, M.-J.; Wang, H.-K.; Zheng, M.-Z.; Xu, J.-J.; Guo, J.-H. Bacillus velezensis, a potential and efficient biocontrol agent in control of pepper gray mold caused by Botrytis cinerea. Biol. Control 2018, 126, 147–157. [Google Scholar] [CrossRef]
- Chen, L.; Hao, S.; Junying, H.; Dianxuan, W.; Ke, B. Antimicrobial, plant growth-promoting and genomic properties of the peanut endophyte Bacillus velezensis LDO2. Microbiol. Res. 2019, 218, 41–48. [Google Scholar] [CrossRef] [PubMed]
- Alsayed, A.; Floriane, L.; Eliane, A.M.; Laure, W. Disease Inhibiting Effect of Strain Bacillus subtilis EG21 and Its Metabolites Against Potato Pathogens Phytophthora infestans and Rhizoctonia solani. Biol. Control Microb. Ecol. 2022, 112, 1943–7684. [Google Scholar] [CrossRef]
- Shin, S.H.; Lim, Y.; Lee, S.E.; Yang, N.W.; RheeSung, J.H. CAS agar diffusion assay for the measurement of siderophores in biological fluids. J. Microbiol. Methods 2001, 44, 89–95. [Google Scholar] [CrossRef]
- Meng, X.-J.; Medison, R.G.; Cao, S.; Wang, L.-Q.; Cheng, S.; Tan, L.-T.; Sun, Z.-X.; Zhou, Y. Isolation, identification, and biocontrol mechanisms of endophytic Burkholderia vietnamiensis C12 from Ficus tikoua Bur against Rhizoctonia solani. Biol. Control 2023, 178, 105132. [Google Scholar] [CrossRef]
- Zhao, P.; Quan, C.; Wang, Y.; Wang, J.; Fan, S. Bacillus amyloliquefaciens Q-426 as a potential biocontrol agent against Fusarium oxysporum f. sp. spinaciae. J. Basic Microbiol. 2014, 54, 448–456. [Google Scholar] [CrossRef]
- Cao, Y.; Zhang, Z.; Ling, N.; Yuan, Y.; Zheng, X.; Shen, B.; Shen, Q. Bacillus subtilis SQR 9 can control Fusarium wilt in cucumber by colonizing plant roots. Biol. Fertil. Soils 2011, 47, 495–506. [Google Scholar] [CrossRef]
- Wen, C.; Peng, H.; Shahzad, M.; Peng, H.; Xing, L.; Yong, L.; Jun, W.; Yi, W.; Li, Y.; Peng, H.; et al. Efficacy of plant growth promoting bacteria Bacillus amyloliquefaciens B9601-Y2 for biocontrol of southern corn leaf blight. Biol. Control 2019, 139, 104080. [Google Scholar] [CrossRef]
- Wu, Y.C.; Zhou, J.Y.; Li, C.G.; Wu, Y.M. Antifungal and plant growth promotion activity of volatile organic compounds produced by Bacillus amyloliquefaciens. MicrobiologyOpen 2019, 8, e00913. [Google Scholar] [CrossRef]
- Sharma, S.R.; Kolte, S.J. Effect of soil-applied NPK fertilizers on severity of black spot disease (Alternaria brassicae) and yield of oilseed rape. Plant Soil 1994, 167, 313–320. [Google Scholar] [CrossRef]
- Lou, S.; Li Feng, Y.; Tian, G.; Wang, H.; Tian, Z.; Wang, L.; Liu, X.; Wang, H. Evaluation of Germplasms for Resistance to Potato Late Blight and Molecular Markers Assisted Screening. Crops 2021, 37, 196–201. [Google Scholar] [CrossRef]
- Manoj, K.S.; Amrita, S.R.; Rajesh, K.S.; Sudheer, K.; Akhilesh, K.P.; Alok, K.S.; Dilip, K.A. Characterization of mycolytic enzymes of Bacillus strains and their bio-protection role against Rhizoctonia solani in tomato. Curr. Microbiol. 2012, 65, 330–336. [Google Scholar] [CrossRef]
- Weinhold, A.R. Rhizoctonia disease of potato: Effect on yield and control by seed tuber treatment. Plant Dis. 1982, 66, 815. [Google Scholar] [CrossRef]
- Xu, W.; Yang, Q.; Yang, F.; Xie, X.; Goodwin, P.H.; Deng, X.X.; Tian, B.M.; Yang, L.Y. Evaluation and genome analysis of Bacillus subtilis YB-04 as a potential biocontrol agent against Fusarium wilt and growth promotion agent of Cucumber. Front. Microbiol. 2022, 13, 885430. [Google Scholar] [CrossRef]
- Saha, S.; Begum, H.H.; Nasrin, S.; Samad, R. Effects of drought stress on pigment and protein contents and antioxidant enzyme activities in five varieties of rice (Oryza sativa L.). Bangladesh J. Bot. 2020, 49, 997–1002. [Google Scholar] [CrossRef]
- Huang, Y.; Wu, Z.; He, Y.; Ye, B.-C.; Li, C. Rhizospheric Bacillus subtilis Exhibits Biocontrol Effect against Rhizoctonia solani in Pepper (Capsicum annuum). BioMed Res. Int. 2017, 2017, 9397619. [Google Scholar] [CrossRef] [PubMed]
- Huang, J.F.; Zhang, F.B.; Pang, Y.W.; Huang, Q.Y.; Tang, S.H.; Fu, H.T.; Yang, B.M. Inhibition of banana Fusarium wilt by two biocontrol agents. Microbiol. China 2017, 44, 835–844. [Google Scholar] [CrossRef]
- Manoj, K.S.; Sudheer, K.; Akhilesh, K.P.; Supriya, S.; Rajesh, K.S.; Prem, L.K.; Srivastava, A.K.; Dilip, K.A. Diversity and antagonistic potential of Bacillus spp. associated to the rhizosphere of tomato for the management of Rhizoctonia solani. Biocontrol Sci. Technol. 2012, 22, 203–217. [Google Scholar] [CrossRef]
- Hyun, M.W.; Yeo, H.Y.; Jun, Y.K.; Seong, H.K. Fungal and Plant Phenylalanine Ammonia-lyase. Mycobiology 2011, 39, 257–265. [Google Scholar] [CrossRef] [PubMed]
- Cazorla, F.M.; Romero, D.; Pérez-García, A.; Lugtenberg, B.J.J.; Vicente, A.; Bloemberg, G. Isolation and characterization of antagonistic Bacillus subtilis strains from the avocado rhizoplane displaying biocontrol activity. J. Appl. Microbiol. 2007, 103, 1950–1959. [Google Scholar] [CrossRef] [PubMed]
- Nihorimbere, V.; Patrick, F.; Philippe, T.; Marc, O. Ecological fitness of Bacillus subtilis BGS3 regarding production of the surfactin lipopeptide in the rhizosphere. Environ. Microbiol. Rep. 2009, 1, 124–130. [Google Scholar] [CrossRef] [PubMed]
- Stéphane, C.; Christophe, C.; Angela, S. Plant growth-promoting bacteria in the rhizo- and endosphere of plants: Their role, colonization, mechanisms involved and prospects for utilization. Soil Biol. Biochem. 2009, 42, 669–678. [Google Scholar] [CrossRef]
- Khalid, A.; Arshad, M.; Zahir, Z.A. Screening plant growth promoting rhizobacteria for improving growth and yield of wheat. J. Appl. Microbiol. 2004, 96, 473–480. [Google Scholar] [CrossRef] [PubMed]
- Thakuria, D.; Talukdar, N.C.; Goswami, C.; Hazarika, S.; Boro, R.C.; Khan, M.R. Characterization and screening of bacteria from rhizosphere of rice grown in acidic soils of Assam. Curr. Sci. 2004, 86, 978–985. [Google Scholar]
- Ramarathnam, R.; Shen, B.; Yu, C.; Dilantha, F.W.G.; Gao, X.; Teresa, D.K. Molecular and biochemical detection of fengycin- and bacillomycin D-producing Bacillus spp., antagonistic to fungal pathogens of canola and wheat. Can. J. Microbiol. 2007, 53, 901–911. [Google Scholar] [CrossRef]
- Marc, O.; Philippe, J. Bacillus lipopeptides: Versatile weapons for plant disease biocontrol. Trends Microbiol. 2007, 16, 115–125. [Google Scholar] [CrossRef]
- Athukorala, S.N.P.; Dilantha, F.W.G.; Khalid, Y.R. Identification of antifungal antibiotics of Bacillus species isolated from different microhabitats using polymerase chain reaction and MALDI-TOF mass spectrometry. Can. J. Microbiol. 2009, 55, 1021–1032. [Google Scholar] [CrossRef]
- Kim, P.I.; Jaewon, R.; Young, H.K.; Youn, T.C. Production of biosurfactant lipopeptides Iturin A, fengycin and surfactin A from Bacillus subtilis CMB32 for control of Colletotrichum gloeosporioides. J. Microbiol. Biotechnol. 2010, 20, 138–145. [Google Scholar] [CrossRef] [PubMed]
- Raaijmakers, J.M.; Irene, D.B.; Ole, N.; Marc, O. Natural functions of lipopeptides from Bacillus and Pseudomonas: More than surfactants and antibiotics. FEMS Microbiol. Rev. 2010, 34, 1037–1062. [Google Scholar] [CrossRef] [PubMed]
- Arguelles, A.A.; Marc, O.; Badre, H.; Yan, L.; Alain, B.; Bernard, J.; Patrick, F. Bacillus amyloliquefaciens GA1 as a source of potent antibiotics and other secondary metabolites for biocontrol of plant pathogens. Microb. Cell Factories 2009, 8, 63. [Google Scholar] [CrossRef] [PubMed]
- Ongena, M.; Emmanuel, J.; Akram, A.; Michel, P.; Alain, B.; Bernard, J.; Jean, L.A.; Philippe, T. Surfactin and fengycin lipopeptides of Bacillus subtilis as elicitors of induced systemic resistance in plants. Environ. Microbiol. 2007, 9, 1084–1090. [Google Scholar] [CrossRef]
- Chen, X.H.; Scholz, R.; Borriss, M.; Junge, H.; Mögel, G.; Kunz, S.; Borriss, R. Difficidin and bacilysin produced by plant-associated Bacillus amyloliquefaciens are efficient in controlling fire blight disease. J. Biotechnol. 2008, 140, 38–44. [Google Scholar] [CrossRef]

| Bacillus Strains | Treatment Group Diameter (cm) | Control Diameter (cm) | Inhibition Ratio (%) |
|---|---|---|---|
| Bacillus subtilis | 3.59 ± 0.07 | 9.00 ± 0.01 | 60.11 a |
| Paenibacillus polymyxa | 3.48 ± 0.13 | 9.00 ± 0.01 | 61.33 a |
| Bacillus amyloliquefaciens | 3.55 ± 0.09 | 9.00 ± 0.01 | 60.56 a |
| Bacillus megaterium | 3.60 ± 0.10 | 9.00 ± 0.01 | 60.00 a |
| Bacillus mucilaginosus | 3.78 ± 0.06 | 9.00 ± 0.01 | 58.00 b |
| Brevibacillus laterosporus | 9.00 ± 0.01 | 9.00 ± 0.01 | 0.00 c |
| Biocontrol Bacteria | Fermentation Broth Concentration | |||
|---|---|---|---|---|
| 10% | 20% | 50% | ||
| P. polymyxa YF | Control group | 8.15 ± 0.06 | 7.95 ± 0.05 | 8.65 ± 0.02 |
| Treatment group | 7.05 ± 0.04 | 4.35 ± 0.09 | 1.25 ± 0.07 | |
| Inhibition rate (%) | 13.50 c | 45.28 b | 85.55 a | |
| B. amyloliquefaciens HT | Control group | 7.85 ± 0.15 | 8.15 ± 0.16 | 8.75 ± 0.21 |
| Treatment group | 7.50 ± 0.09 | 4.50 ± 0.18 | 1.50 ± 0.17 | |
| Inhibition rate (%) | 4.46 c | 44.79 b | 82.86 a | |
| Treatment | MDRx | ijy | ij | Control Effect (%) | ij | |
|---|---|---|---|---|---|---|
| Lower | Upper | |||||
| Blank Control | 0.00 | 5.50 | 0.13 | - | 0.13 | 0.13 |
| Negative Control | 8.80 | 35.50 | 0.88 | - | 0.85 | 0.90 |
| Prevention Group | 1.40 | 21.00 | 0.51 | 59.23 ± 0.14 a | 0.44 | 0.59 |
| Treatment Group | 1.20 | 20.00 | 0.49 | 52.76 ± 0.05 a | 0.43 | 0.54 |
| Treatment | MDRx | ijy | ij | Control Effect (%) | ij | |
|---|---|---|---|---|---|---|
| Lower | Upper | |||||
| Blank Control | 0.00 | 5.50 | 0.08 | - | 0.08 | 0.08 |
| Negative Control | 8.20 | 54.50 | 0.90 | - | 0.85 | 0.95 |
| YF Prevention Group | 4.00 | 26.50 | 0.43 | 56.03 ± 0.43 a | 0.33 | 0.54 |
| YF Treatment Group | 5.80 | 41.00 | 0.68 | 53.43 ± 0.24 ab | 0.58 | 0.77 |
| HT Prevention Group | 3.40 | 22.40 | 0.37 | 50.50 ± 0.20 ab | 0.26 | 0.47 |
| HT Treatment Group | 4.80 | 33.10 | 0.54 | 43.33 ± 0.18 b | 0.43 | 0.65 |
Disclaimer/Publisher’s Note: The statements, opinions and data contained in all publications are solely those of the individual author(s) and contributor(s) and not of MDPI and/or the editor(s). MDPI and/or the editor(s) disclaim responsibility for any injury to people or property resulting from any ideas, methods, instructions or products referred to in the content. |
© 2024 by the authors. Licensee MDPI, Basel, Switzerland. This article is an open access article distributed under the terms and conditions of the Creative Commons Attribution (CC BY) license (https://creativecommons.org/licenses/by/4.0/).
Share and Cite
Lan, Q.; Liu, Y.; Mu, R.; Wang, X.; Zhou, Q.; Islam, R.; Su, X.; Tian, Y. Biological Control Effect of Antagonistic Bacteria on Potato Black Scurf Disease Caused by Rhizoctonia solani. Agronomy 2024, 14, 351. https://doi.org/10.3390/agronomy14020351
Lan Q, Liu Y, Mu R, Wang X, Zhou Q, Islam R, Su X, Tian Y. Biological Control Effect of Antagonistic Bacteria on Potato Black Scurf Disease Caused by Rhizoctonia solani. Agronomy. 2024; 14(2):351. https://doi.org/10.3390/agronomy14020351
Chicago/Turabian StyleLan, Qingqing, Yang Liu, Rongrong Mu, Xuetao Wang, Qian Zhou, Rehmat Islam, Xu Su, and Yongqiang Tian. 2024. "Biological Control Effect of Antagonistic Bacteria on Potato Black Scurf Disease Caused by Rhizoctonia solani" Agronomy 14, no. 2: 351. https://doi.org/10.3390/agronomy14020351
APA StyleLan, Q., Liu, Y., Mu, R., Wang, X., Zhou, Q., Islam, R., Su, X., & Tian, Y. (2024). Biological Control Effect of Antagonistic Bacteria on Potato Black Scurf Disease Caused by Rhizoctonia solani. Agronomy, 14(2), 351. https://doi.org/10.3390/agronomy14020351

